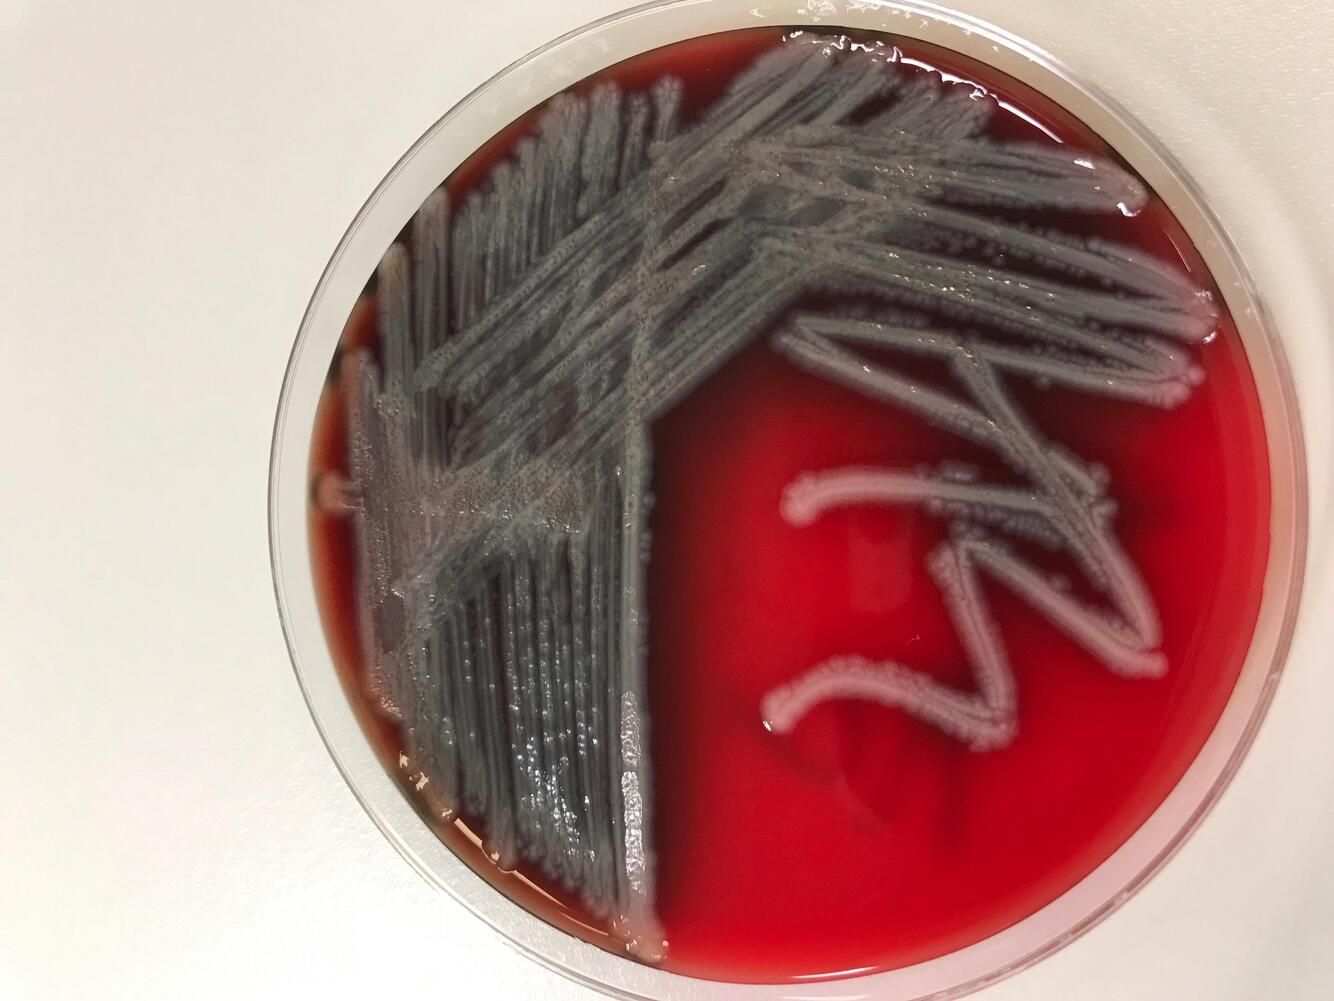
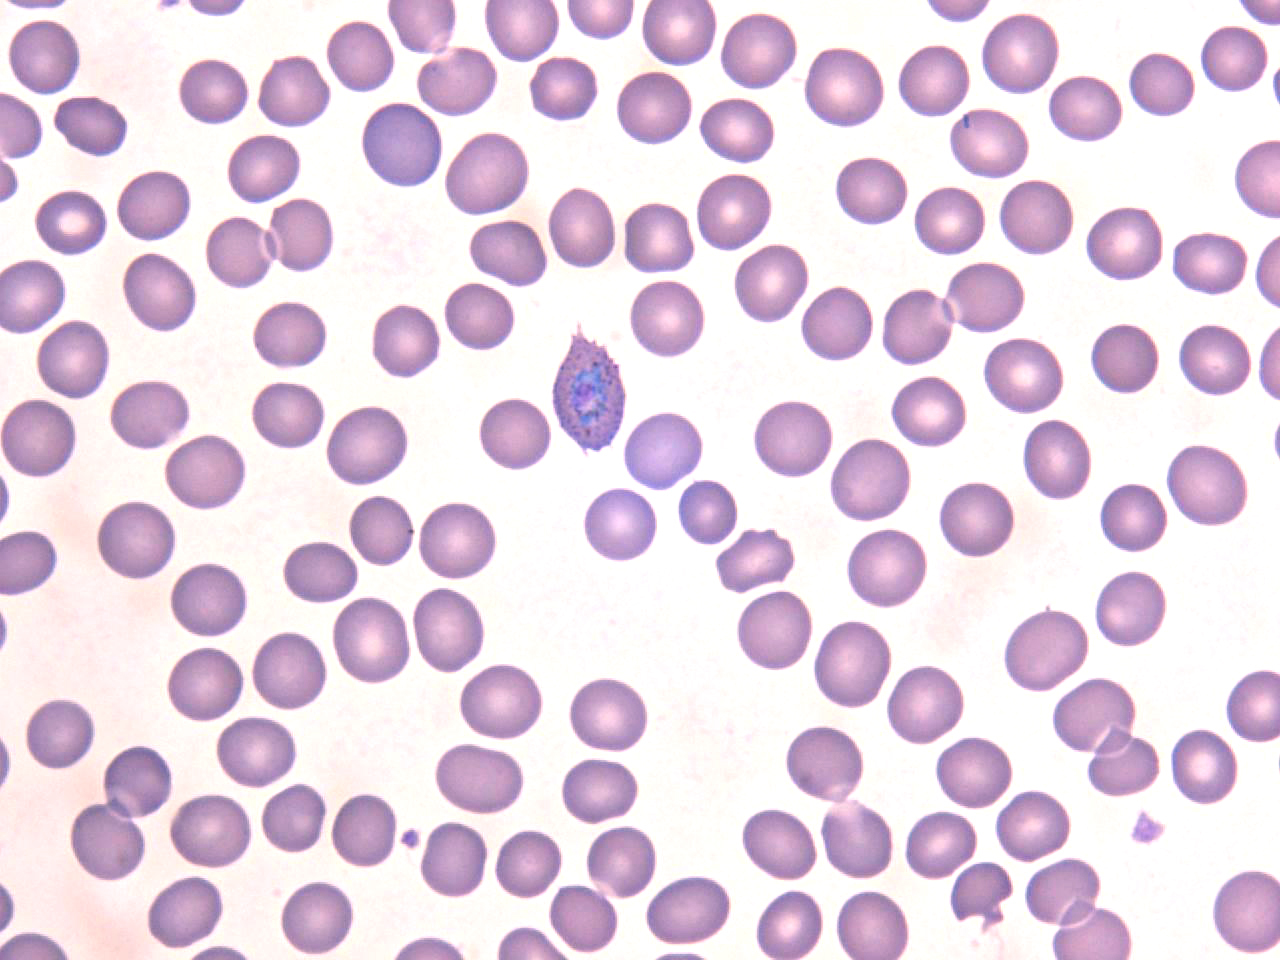

Lung

meningothelial-like nodule (MLN)
Lung

Alveolar adenoma
Blood Agar
Metallic sheen; Pseudomonas aeruginosa
GMS Stain Lung

blastomycosis
“Spherical yeasts measuring approximately 12 µm with double contour walls and broad based budding”
blastomycosis
Rat-bite fever is primarily caused by
Streptobacillus moniliformis
Which genes confers resistance to colistin?
mcr-1 gene
blaKPC gene confers resistance to
beta-lactam antibiotics
mecA gene confers resistance to
beta-lactam antibiotics via production of the low-affinity penicillin binding protein (PBP2a)
erm gene confers resistance to
erythromycin and clindamycin (detected by erythromycin mediated induction) via ribosome methylation
Which species of plasmodium are capable of creating dormant hypnozoites in the host liver?
Plasmodium ovale and Plasmodium vivax
Peripheral Blood Smear
coarse basophilic stippling and an infected red blood cell with a fimbriated membrane; Plasmodium ovale
Which species of plasmodium causes “Blackwater Fever” and severe neurologic disease?
Plasmodium falciparum
Which Enterococcus species are considered intrinsically resistant to vancomycin?
Enterococcus gallinarum and Enterococcus casseliflavus
What mutation in Gastric MALT lymphoma associated with chronic gastritis secondary to Helicobacter pylori infection makes it refractory to antibiotic treatment?
t(11;18)(q21;q21) (API2-MALT1)
Clear cell sarcoma Translocation
(12;22)(q13;q12) EWSR1-ATF1
Lynch Syndrome is most often caused by mutations in
MSH6 or MLH1
Lynch Syndrome associated with which cancers
Colorectal, endometrial, ovarian
Translocation in myxoid and round cell liposarcoma
t(12;16)(q13;p11) DDIT3-FUS
Most cases of acute myeloid leukemia (AML) in Down Syndrome are what subtype
acute megakaryoblastic leukemia
Guidelines for the detection of malignancy of bladder cancer with FISH?
If ≥4 cells show gains for two or more chromosomes, or if ≥12 cells have zero 9p21 signals within the first 25 cells analyzed; analysis should continue until either the criteria for malignancy are met or until the entire specimen has been analyzed
ALK+ anaplastic large cell lymphoma translocation
t(1;2) (TPM3-ALK)
Translocation in Extraskeletal myxoid chondrosarcoma (EMC)
t(9;22) (EWS-CHN)
chronic myeloid leukemia
t(9;22) (BCR-ABL)









